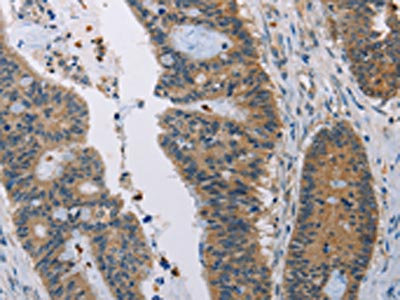

AMBP Antibody
-
中文名稱:AMBP兔多克隆抗體
-
貨號(hào):CSB-PA083278
-
規(guī)格:¥1100
-
圖片:
-
The image on the left is immunohistochemistry of paraffin-embedded Human colon cancer tissue using CSB-PA083278(AMBP Antibody) at dilution 1/35, on the right is treated with fusion protein. (Original magnification: ×200)
-
The image on the left is immunohistochemistry of paraffin-embedded Human liver cancer tissue using CSB-PA083278(AMBP Antibody) at dilution 1/35, on the right is treated with fusion protein. (Original magnification: ×200)
-
-
其他:
產(chǎn)品詳情
-
Uniprot No.:
-
基因名:AMBP
-
別名:A1M antibody; Alpha 1 microglobulin/bikunin precursor antibody; Alpha 1 microglycoprotein antibody; Alpha-1 microglycoprotein antibody; Alpha-1-microglobulin antibody; AMBP antibody; AMBP_HUMAN antibody; Bikunin antibody; Complex-forming glycoprotein heterogeneous in charge antibody; EDC1 antibody; Growth inhibiting protein 19 antibody; HCP antibody; HI-30 antibody; HI30 antibody; IATIL antibody; ITI antibody; ITI-LC antibody; ITIL antibody; Microglobulin (alpha 1) antibody; Protein AMBP antibody; Protein HC antibody; Trypstatin antibody; Uristatin antibody; Uronic-acid-rich protein antibody; UTI antibody
-
宿主:Rabbit
-
反應(yīng)種屬:Human
-
免疫原:Fusion protein of Human AMBP
-
免疫原種屬:Homo sapiens (Human)
-
標(biāo)記方式:Non-conjugated
-
抗體亞型:IgG
-
純化方式:Antigen affinity purification
-
濃度:It differs from different batches. Please contact us to confirm it.
-
保存緩沖液:-20°C, pH7.4 PBS, 0.05% NaN3, 40% Glycerol
-
產(chǎn)品提供形式:Liquid
-
應(yīng)用范圍:ELISA,IHC
-
推薦稀釋比:
Application Recommended Dilution ELISA 1:2000-1:5000 IHC 1:25-1:100 -
Protocols:
-
儲(chǔ)存條件:Upon receipt, store at -20°C or -80°C. Avoid repeated freeze.
-
貨期:Basically, we can dispatch the products out in 1-3 working days after receiving your orders. Delivery time maybe differs from different purchasing way or location, please kindly consult your local distributors for specific delivery time.
-
用途:For Research Use Only. Not for use in diagnostic or therapeutic procedures.
相關(guān)產(chǎn)品
靶點(diǎn)詳情
-
功能:Inter-alpha-trypsin inhibitor inhibits trypsin, plasmin, and lysosomal granulocytic elastase. Inhibits calcium oxalate crystallization.; Trypstatin is a trypsin inhibitor.
-
基因功能參考文獻(xiàn):
- There were significantly higher serum concentrations of fetal hemoglobin and alpha1-microglobulin and significantly lower first trimester serum concentrations of hemopexin in patients who later developed preeclampsia. PMID: 27155336
- Prophylactic UTI maintains the endothelial barrier function, increases VE-cadherin expression, and inhibits the phosphorylation of VE-cadherin at Tyr658 under inflammatory conditions PMID: 26681130
- Data suggest that Mg2+ or Mn2+ (but not Ca2+) induce a conformational change in inter-alpha-inhibitor (ITIH1 and ITIH2) and a bikunin/chondroitin sulfate-dependent increase in thermodynamic stability; bikunin binds adjacent to the two heavy chains. PMID: 26728454
- Data indicate that two heme groups can be bound simultaneously at separate sites in the antioxidant alpha1-microglobulin. PMID: 26497278
- results indicate a reduced UTI level in CSF of MS and NMO patients. The levels were associated with the severity of the two demyelinating diseases during relapse PMID: 25555815
- Proximal tubular dysfunction, indicated by urine alpha1-microglobulin, was independently associated with kidney function decline in HIV-infected and uninfected women and mortality risk among HIV-infected women. PMID: 25370597
- placental alpha microglobulin-1 is a sensitive and specific test to assess rupture of membranes in patients with an equivocal diagnosis based on simple tests PMID: 24698819
- Heavy chain transfer by tumor necrosis factor-stimulated gene 6 to the bikunin proteoglycan. PMID: 25561734
- Decreased bikunin mRNA level in renal cells might be associated with poor prognosis of renal carcinoma. PMID: 24980765
- The antioxidative protection of cells and collagen by A1M is totally dependent on its C34 amino acid residue. PMID: 23642167
- Label-free quantitative comparison of DN urinary exosomes vs control group and SRM further validation, resulted in the discovery of a panel of three proteins (AMBP, MLL3 and VDAC1) which changes in DN. PMID: 24211404
- The high level of serum AMBP could predict the poor response of the AGC patients. PMID: 24135868
- In pre-term pregnant women with intact membranes, placental alpha-microglobulin-1 in cervicovaginal fluid test rates are more positive in cases of uterine contraction. PMID: 23919851
- our findings suggest that urine bikunin level, as well as proteinuria, could represent a useful parameter for monitoring renal function in those patients that do not present any symptoms of renal insufficiency. PMID: 23841057
- Determined is the first structure of human alpha-1-microglobulin with heavy electron density of the chromophore. PMID: 24012674
- Sulfation of the bikunin chondroitin sulfate chain determines heavy chain.hyaluronan complex formation PMID: 23801333
- High urine alpha-1-microglobulin is associated with interstitial fibrosis and tubular atrophy plus inflammation. PMID: 23414180
- High urine alpha-1-microglobulin is associated with ischemic acute tubular necrosis than other causes of acute kidney injury. PMID: 23324582
- Report prognostic value of urinary alpha 1-macroglobulin in idiopathic membranous nephropathy. PMID: 22595828
- crystal of alpha1-microglobulin belonged to space group P4(3), with unit-cell parameters a = b = 36.45, c = 112.68 A PMID: 22684072
- The results suggest that A1M may have a physiological role in protection of skin cells and matrix against oxidative damage following bleeding. PMID: 22096585
- urinary marker for the differential diagnosis of Balkan endemic nephropathy PMID: 21332340
- These findings suggest that there was no significant association in genotype distribution of Init-2 polymorphism of the AMBP gene between patients with kidney stones and healthy controls. PMID: 20602574
- the cell-protective effects of alpha(1)-microglobulin during alpha-particle irradiation PMID: 20954860
- The promoter of AMBP gene had polymorphisms at positions -218 and -189 nt giving three different genotypes with no association between these observed genotypes and kidney stone-forming phenotypes. PMID: 20602574
- increased protein levels in preeclamptic women PMID: 19879940
- significant relationship was established between the low level and absence of bikunin, and pro-u-PA in urine samples from patients with bladder tumors; identified bikunin loss in urine as a potential bladder carcinoma marker PMID: 19914646
- Transfection into H460M Human large cell lung carcinoma line decreased tumor growth and metastasis in nude mice PMID: 11807786
- Processing of the lipocalin alpha(1)-microglobulin by hemoglobin induces heme-binding and heme-degradation properties. PMID: 11877257
- bikunin has a role in downregulating PI3 kinase and suppressing tumor invasiveness and metastasis in ovaran cancer cells PMID: 14597629
- Data show that alpha(1) -microglobulin/bikunin precursor specifically interacts with the ORF3 protein of hepatitis E virus and has a direct role in enhancing alpha(1)microglobulin export from the hepatocyte. PMID: 15037615
- alpha-1-microglobulin is covalently bound to kynurenine-derived chromophores PMID: 15452109
- Bikunin neither decreased expression of TGF-beta receptors (TbetaRI and TbetaRII) in cancer cells nor altered the specific binding of 125I TGF-beta1 to the cells. PMID: 15498571
- The TSG-6 and inter-alpha-inhibitor interaction promotes a transesterification cleaving the protein-glycosaminoglycan-protein (PGP) cross-link. PMID: 15653696
- the second processed protein from AMBP, bikunin, strongly interacted with the full-length hepatitis E virus ORF3 protein PMID: 16140784
- the ORF3 protein exploits the endosomal sorting machinery to enhance the secretion of an immunosuppressant molecule (alpha1 microglobulin) from cultured hepatocytes PMID: 16407257
- Identification of the protein bikunin as an endogenous, competitive inhibitor of a dynorphin-converting enzyme in human cerebrospinal fluid. PMID: 17087727
- Free uristatin and bikunin pass readily into urine and are primarily bound to heavy chains that constitute the proinhibitor form in plasma. PMID: 17115277
- Bikunin was found to localize on the cell membrane, while tryptase was in the secretary granules of the mast cells from psoriatic lesions. PMID: 17146627
- alpha(1)-microglobulin participates in the defense against oxidation by hemoglobin, heme, and reactive oxygen species PMID: 17320766
- small angle X-ray scanning study of the monomer and dimer forms of alpha1-microglobulin; monomer is characterised by a radius of gyration R(G)= 2.20 nm and D(max)=6.3 nm and the dimer by R(G)=2.99 nm and D(max)=9.5 nm PMID: 17584166
- The ability of alpha-1-microglobulin to restore the initial conformation characteristic for the native protein and the internal dynamics after the unfolding of the globule by 10 M urea and 6 M guanidine hydrochloride has been ascertained. PMID: 17633530
- AMBP has radical scavenging activity. PMID: 17766242
- urinary trypsin inhibitor is insufficiently produced for neutrophil elastase release after cardiac arrest PMID: 17998887
- in multiple myeloma patients without renal failure, elevated Alpha-1-microglobulin excretion might be an early marker of renal tubular involvement PMID: 18046670
- In the present study, structural motifs regulating bikunin's anti-inflammatory function are delineated. Binding of bikunin to neutrophils is critically important for its anti-inflammatory capacity. PMID: 18226914
- The transfer of heavy chains from bikunin proteins to hyaluronan requires both TSG-6 and HC2. PMID: 18448433
- Overexpression of bikunin reduced the gene expression of matriptase, which attenuated in vitro cell invasion in prostate cancer. PMID: 18649735
- Overexpression of Urinary trypsin inhibitor is associated with recurrence in hepatocellular carcinoma. PMID: 19636634
顯示更多
收起更多
-
亞細(xì)胞定位:Secreted.
-
蛋白家族:Calycin superfamily, Lipocalin family
-
組織特異性:Expressed by the liver and secreted in plasma. Alpha-1-microglobulin occurs in many physiological fluids including plasma, urine, and cerebrospinal fluid. Inter-alpha-trypsin inhibitor is present in plasma and urine.
-
數(shù)據(jù)庫鏈接:
Most popular with customers
-
-
YWHAB Recombinant Monoclonal Antibody
Applications: ELISA, WB, IHC, IF, FC
Species Reactivity: Human, Mouse, Rat
-
Phospho-YAP1 (S127) Recombinant Monoclonal Antibody
Applications: ELISA, WB, IHC
Species Reactivity: Human
-
-
-
-
-